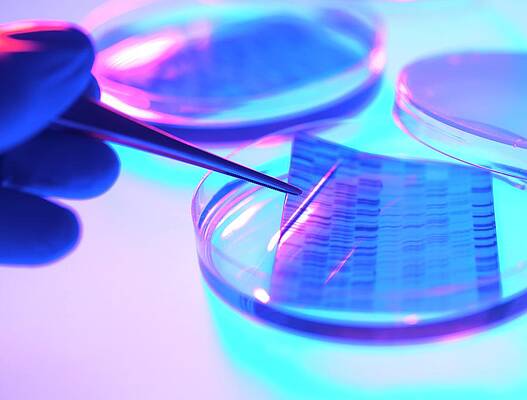
Wall Art - Photograph - Dna Research by Tek Image

Housse Clip Art North American Continent Nevada Clip Art

Black Map of Washington, D.C. Digital Art
Naxart Studio ![]()
$22

White Map of Washington, D.C. Digital Fine art
Naxart Studio ![]()
$22

Seattle Scarlet Subway Map Digital Fine art
Naxart Studio ![]()
$22

Seattle Orange Subway Map Digital Art
Naxart Studio ![]()
$22

Washington D.C. Ruby Subway Map Digital Art
Naxart Studio ![]()
$22

Washington D.C. Yellow Subway Map Digital Art
Naxart Studio ![]()
$22

Washington D.C. Orange Subway Map Digital Art
Naxart Studio ![]()
$22

Washington D.C. Blackness Subway Map Digital Art
Naxart Studio ![]()
$22

Washington D.C. White Subway Map Digital Art
Naxart Studio ![]()
$22

Rosa Parks Gets Fingerprinted Photograph
Underwood Archives ![]()
$25

Map Of The Atlantic Coasts Photograph
Library Of Congress, Geography And Map Division ![]()
$44

Continents 150 Million Years Agone Photograph
Claus Lunau ![]()
$44

1827 Finley Map of Mississippi Photograph
Paul Fearn ![]()
$42

St. Louis Fundamental Short Flood Photograph
Underwood Athenaeum ![]()
$25

North Carolina Map Art with Flag Blueprint Digital Art
World Art Prints And Designs ![]()
$22

Antique Map of N America Drawing
Guillaume Raynal ![]()
$22

Downtown Tulsa Skyline on the Freeway Photograph
Gregory Ballos ![]()
$53

Americas At Night Photograph
Nasa Globe Observatory/joshua Stevens/miguel Roman/gsfc/scientific discipline Photograph Library ![]()
$44

Map Of The Americas Photo
Library Of Congress, Geography And Map Division/science Photo Library ![]()
$44

Oil Well Photograph
Library Of Congress/science Photo Library ![]()
$44

Dawn Over Northward America Photograph
Joe Tucciarone ![]()
$44

American Flag Flying Over Brooklyn Photograph
Panoramic Images ![]()
$37

North America Photograph
Nasa/gsfc-svs/science Photo Library ![]()
$44

Northward America At Night Photograph
Nasa/science Photo Library ![]()
$44

North America Photograph
Nasa/noaa/scientific discipline Photo Library ![]()
$44

North America Portolan Chart Photograph
Library Of Congress, Geography And Map Division/science Photo Library ![]()
$44

North America Photograph
Planetobserver/science Photo Library ![]()
$44

Northward America Photograph
Dynamic Earth Imaging/scientific discipline Photo Library ![]()
$44

North America Photograph
Nasa/gsfc-svs/science Photo Library ![]()
$44

North America With Cloud Photograph
Planetobserver/scientific discipline Photo Library ![]()
$44

North Atlantic Ocean Seafloor Map Photograph
Martin Jakobsson/science Photo Library ![]()
$44

North America Photograph
Planetobserver/science Photo Library ![]()
$44

Spanish North America Photograph
Library Of Congress/scientific discipline Photo Library ![]()
$44

North America Photograph
Nasa/noaa/science Photo Library ![]()
$44

North America Photo
Planetobserver/scientific discipline Photo Library ![]()
$44

North And South America Photograph
Library Of Congress, Geography And Map Division/science Photograph Library ![]()
$44

Northward And Due south America Photo
Planetary Visions Ltd/science Photograph Library ![]()
$44

N America At Night Photo
Nasa/noaa/science Photo Library ![]()
$44

North And Southward America Photograph
Library Of Congress, Geography And Map Partition/science Photo Library ![]()
$44

Map Of N America Photograph
Collection Abecasis/scientific discipline Photo Library ![]()
$44

Carbon Footprints Of Due north American Cities Photograph
Nasa Globe Observatory/science Photo Library ![]()
$44

Due north America Photograph
Kateryna Kon/science Photo Library ![]()
$44

The Uprising of the North Painting
Thomas Nast ![]()
$32

Movement Of Earth's Continents Photograph
Tim Brown/science Photo Library ![]()
$44

Due north America Painting
CMR Bonne ![]()
$17

Antiquarian Map of America Drawing
Jodocus Hondius ![]()
$22

Gobal Decline Photograph
Victor De Schwanberg ![]()
$44

NY Commemoration Of St. Paulino Photograph
Underwood Archives ![]()
$25

A member of the cavalry poses standing in front of his equus caballus Photograph
Underwood Athenaeum ![]()
$25

Bounding main Currents Photograph
Ballad & Mike Werner ![]()
$44

Ocean Currents Photograph
Carol & Mike Werner ![]()
$44
Deoxyribonucleic acid Research Photograph
Tek Image ![]()
$44

World Fourth dimension Zones Photograph
Library Of Congress, Geography And Map Division ![]()
$44

17th Century Map Of America Photo
Lawrence H. Slaughter Collection Of English Maps, Charts, Globes, Books And Atlases/new York Public Library ![]()
$44

Atlantic Ocean Currents Photograph
Carol & Mike Werner ![]()
$44

Atlantic Bounding main Currents Photograph
Carol & Mike Werner ![]()
$44

Map Of The Americas Photo
Library Of Congress, Geography And Map Division ![]()
$44

Historic Brooklyn Bridge, New York Photograph
Panoramic Images ![]()
$37

Historic Brooklyn Span, New York Photograph
Panoramic Images ![]()
$37

Earth'due south Topography Photograph
Noaa/science Photograph Library ![]()
$44

Earth At Night Photograph
Nasa World Observatory/miguel Roman/gsfc/science Photo Library ![]()
$44

Earth's Topography Photo
Noaa/science Photograph Library ![]()
$44

Earth's Topography Photograph
Noaa/science Photo Library ![]()
$44

Earth'due south Topography Photograph
Noaa/science Photograph Library ![]()
$44

Earth'south Topography Photograph
Noaa/science Photograph Library ![]()
$44

Global Tectonics Photograph
Karsten Schneider/scientific discipline Photo Library ![]()
$44

Earth's Topography Photograph
Noaa/scientific discipline Photo Library ![]()
$44

Kircher's Geological World Map Photograph
Purple Astronomical Society/science Photo Library ![]()
$44

Earth's Topography Photo
Noaa/science Photograph Library ![]()
$44

Global Tectonics Photo
Karsten Schneider/scientific discipline Photo Library ![]()
$44

The Groovy Lakes Photograph
Planetary Visions Ltd/science Photo Library ![]()
$44

Earth Photograph
Planetary Visions Ltd/scientific discipline Photo Library ![]()
$44
borkholderuposecushers.blogspot.com
Source: https://pixels.com/art/north+american+continent
Post a Comment for "Housse Clip Art North American Continent Nevada Clip Art"